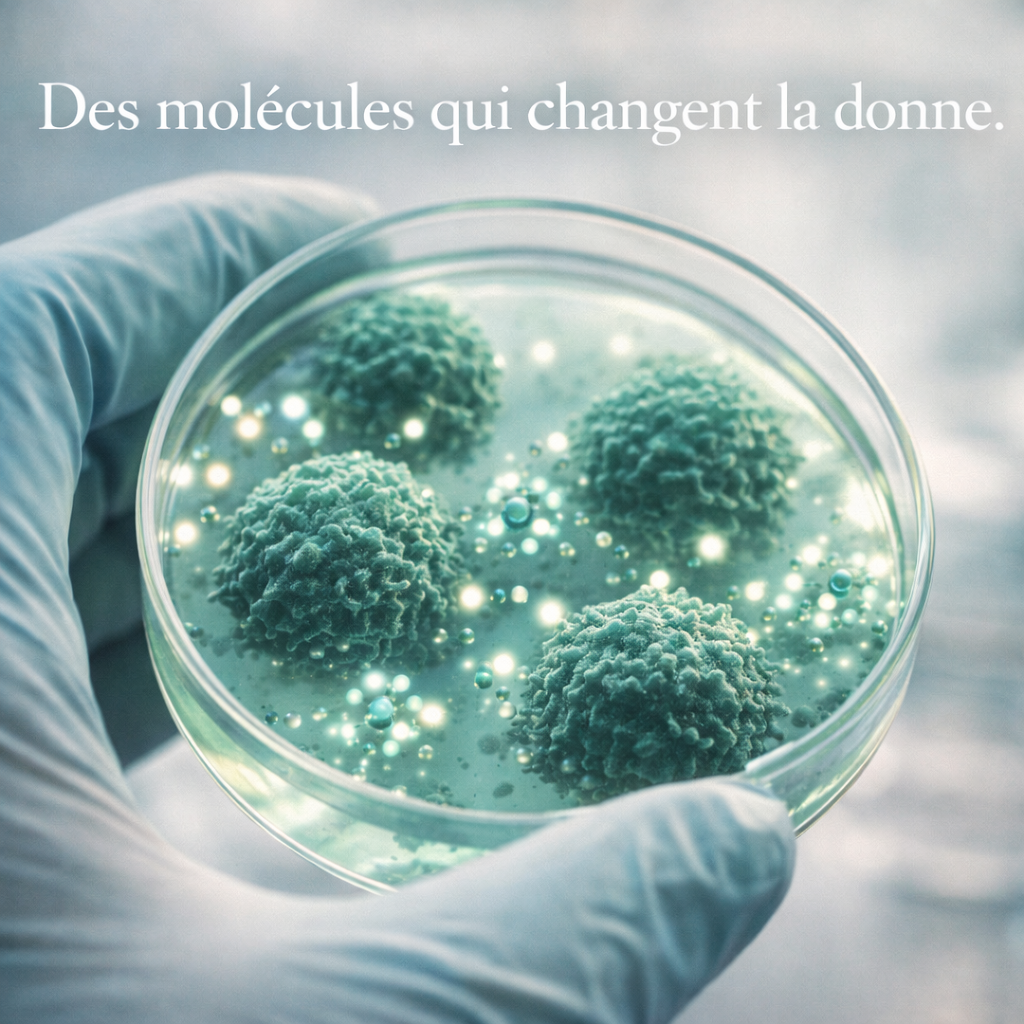

Le cancer. Un mot qui glace le sang, une bataille incessante pour la vie.
Des milliards sont investis chaque année dans la recherche de traitements innovants, des laboratoires high-tech aux essais cliniques de pointe. Pourtant, au milieu de cette quête effrénée, une vérité dérangeante émerge : des pistes fascinantes semblent délibérément ignorées. Des molécules anciennes, dont le profil de sécurité est établi. Elles montrent des promesses silencieuses.
C’est le paradoxe troublant de l’ivermectine et du fenbendazole. Longtemps reléguées au rôle d’antiparasitaires, ces substances déclassées révèlent un potentiel anticancéreux intrigant.
La frustration est palpable: des indices puissants émergent, mais se heurtent à une indifférence institutionnelle.
Pourquoi alors sont-elles si peu étudiées ?
Pourquoi le débat scientifique autour d’elles est-il assourdi, voire activement censuré ?
Inspiré notamment par des analyses comme celle de « Ivermectin and Fenbendazole: The Cancer Treatments Big Pharma Fears » sur Substack, cet article plonge dans les zones d’ombre d’une recherche sous influence, appelant à une science libre de tout conflit d’intérêts pour le bien de tous.
Les promesses silencieuses de l’ivermectine et du fenbendazole
Considérons un instant: des médicaments génériques, peu coûteux, utilisés depuis des décennies avec une toxicité minime.
L’ivermectine, prix Nobel de médecine en 2015 pour son action antiparasitaire, et le fenbendazole, un antihelminthique vétérinaire, sont de ceux-là.
Leur réputation bien établie dans la lutte contre les parasites cache un secret bien gardé : leur potentiel dans le domaine de l’oncologie.
Des dizaines d’études in vitro et précliniques ont tiré la sonnette d’alarme, positivement. L’ivermectine a montré une capacité à inhiber la prolifération de diverses cellules cancéreuses.
Elle induit l’apoptose (la mort cellulaire programmée) et bloque l’angiogenèse (la formation de nouveaux vaisseaux sanguins qui nourrissent les tumeurs).
Elle agit sur des voies de signalisation cruciales impliquées dans la croissance tumorale, comme la voie Wnt/β-caténine et PI3K/Akt.
Son action ne se limite pas à un seul type de cancer. Elle a été explorée pour les cancers du sein, du côlon, du poumon, du pancréas, de la prostate, et même les gliomes. C’est un spectre d’action impressionnant.
Le fenbendazole n’est pas en reste. Ce vermifuge, accessible à tous, a démontré des propriétés anticancéreuses similaires. Il perturbe le métabolisme des cellules cancéreuses. Il agit sur les microtubules, des structures essentielles à la division cellulaire.
En ciblant ces éléments, le fenbendazole peut bloquer la croissance des tumeurs et sensibiliser les cellules résistantes à la chimiothérapie. Des modèles animaux ont confirmé ces effets prometteurs, notamment sur les gliomes et certains cancers digestifs.
Les chercheurs ont observé une réduction significative de la taille des tumeurs et une amélioration de la survie.
C’est une lueur d’espoir. Une lueur trop souvent voilée.
Ces données préliminaires sont fascinantes. Elles ouvrent des perspectives pour des traitements innovants.
Des traitements complémentaires ou alternatifs. Pensons au soulagement qu’une thérapie peu coûteuse et bien tolérée pourrait apporter aux patients.
Le problème?
Elles restent majoritairement au stade des paillasses de laboratoire. Un immense gâchis de potentiel.
Le mur invisible des grands essais cliniques

Si les données in vitro et précliniques sont si encourageantes, pourquoi ne sont-elles pas suivies par de grands essais cliniques chez l’humain ?
Le financement est la clé de voûte de cette énigme.
Le développement d’un nouveau médicament coûte des centaines de millions d’euros. Les essais cliniques, phases cruciales pour évaluer l’efficacité et la sécurité chez l’homme, sont extrêmement onéreux.
Les entreprises pharmaceutiques, majoritairement, investissent là où elles peuvent breveter. Un brevet garantit des années d’exclusivité. Il permet de récupérer les investissements colossaux.
L’ivermectine et le fenbendazole sont des molécules génériques. Elles sont tombées dans le domaine public. Elles ne peuvent plus être brevetées. Cela les rend « non rentables » aux yeux des géants de l’industrie.
Le modèle économique actuel n’est pas conçu pour promouvoir des thérapies peu coûteuses. Il privilégie les innovations brevetables. Même si elles offrent parfois un bénéfice marginal. C’est le nœud du problème.
Un patient aux prises avec un cancer avancé se voit souvent offrir des traitements coûteux. Ces traitements sont parfois lourds d’effets secondaires. L’idée qu’une solution simple et accessible pourrait exister, mais soit ignorée par le système, est une pilule amère à avaler.
Ce manque d’intérêt financier crée un vide criant. Il paralyse la recherche. Il relègue ces molécules à la marge du débat médical dominant.
Les laboratoires universitaires et les institutions publiques ont des budgets limités. Ils peinent à financer des essais de grande envergure. Cette situation conduit à une véritable « censure systémique ».
Elle ne se manifeste pas par une interdiction explicite.
Plutôt par une absence de soutien, de visibilité et de ressources.
Pour mieux comprendre comment ces blocages institutionnels opèrent et les implications pour la santé publique, vous pouvez lire l’article Ivermectine et cancer : traitement alternatif ou tabou mondial ?. Il explore en profondeur les mécanismes de cette marginalisation et les enjeux éthiques sous-jacents.

Découvrez « La guerre contre l’ivermectine », le livre du Dr Pierre Kory, est bien plus qu’un récit médical: c’est une enquête foudroyante sur les manœuvres cachées de Big Pharma et des agences de santé face à un traitement qui pourrait changer votre vie.
Pendant que les autorités sanitaires fermaient les portes à cette molécule, le Dr Kory, une figure majeure de la recherche médicale, risquait sa carrière pour défendre une piste scientifique sérieuse.
1️⃣ Les preuves cliniques ignorées:
Des études scientifiques montrant l’efficacité réelle de l’ivermectine contre le COVID-19. Des données que les autorités refusent d’examiner, que la recherche indépendante confirme, mais que les institutions bloquent.
2️⃣ Comment un médicament Nobel est devenu « persona non grata »:
L’ivermectine a reçu le Prix Nobel de Médecine en 2015. Puis elle est devenue l’ennemi public numéro un. Découvrez les mécanismes de cette déchéance orchestrée: pression médiatique, discrédit, censure.
3️⃣ Le courage face aux pressions:
Comment le Dr Kory a maintenu sa position scientifique face à l’hostilité institutionnelle, aux attaques personnelles et aux conséquences professionnelles.
4️⃣ Les motifs réels : profit contre santé
Comment Big Pharma écrase systématiquement les solutions non-profitables. L’ivermectine ? Un générique bon marché, impossible à breveter.
5️⃣ L’Alliance FLCCC:
Des protocoles de traitement précoce basés sur l’ivermectine qui priorisent le patient plutôt que le profit.
C’est un compagnon indispensable pour quiconque refuse de laisser les institutions décider seules du sort de sa santé.
Découvrez « La guerre contre l’ivermectine » dans notre boutique
—> Code PAGE5 pour 5% de réduction
Entre faits et « fake news »: déconstruire la controverse

La controverse autour de l’ivermectine est devenue virale pendant la pandémie de COVID-19. Elle a été tour à tour saluée comme une panacée et vilipendée comme une dangereuse fumisterie.
Cette polarisation a jeté une ombre sur toute recherche sérieuse. Elle a rendu difficile l’examen objectif de ses propriétés.
Un point essentiel doit être clair: l’absence de preuves cliniques de grande envergure chez l’humain ne constitue pas une preuve d’inefficacité.
Cela signifie simplement que la recherche nécessaire n’a pas été menée. Ou qu’elle est insuffisante.
Les résultats prometteurs in vitro appellent à davantage d’études. Ils ne sont pas une licence pour l’automédication, une démarche toujours risquée. Ils sont une incitation à l’investigation rigoureuse. C’est la voie de la science. La seule voie fiable.
Le défi est immense. Il faut naviguer entre les espoirs fondés sur la science et les dangers de la désinformation.
Il est crucial d’exiger des études transparentes. Des études indépendantes. Des études exemptes de conflits d’intérêts.
La santé publique mérite mieux que des vérités à moitié dites ou des pistes non explorées.
C’est un appel à l’action pour la communauté scientifique et les organismes de financement.
Nous devons briser ce silence. Nous devons ouvrir la voie à une exploration sans entraves.
Pour une perspective plus large sur les attaques infondées contre l’ivermectine et les controverses qui ont émaillé sa reconnaissance, découvrez comment cette molécule a été délibérément mise au ban dans Ivermectine COVID : la vérité explosive de la guerre contre l’ivermectine et les discussions sur la Détox du vaccin ARNm avec l’Ivermectine. Ces articles éclairent le contexte de cette « guerre » contre la molécule.
L’urgence d’une recherche indépendante pour la santé de tous

Le cas de l’ivermectine et du fenbendazole en oncologie est emblématique. Il illustre les limites d’un système de recherche dominé par la logique du profit. C’est une alerte.
Les patients méritent que toutes les pistes soient explorées.
Ils méritent que la science prime sur les intérêts économiques.
Il est temps de remettre l’humain au cœur de la recherche.
Il est temps d’investir dans des études sur des molécules potentiellement révolutionnaires.
Des études, même si elles ne promettent pas des milliards de bénéfices.
La science doit être au service de l’humanité. Non l’inverse. Cela implique un engagement collectif.
Un engagement des gouvernements. Des fondations. Des citoyens. Nous devons financer des recherches décloisonnées. Des recherches transparenantes. Des recherches indépendantes.
Pour que des molécules comme l’ivermectine et le fenbendazole puissent enfin révéler tout leur potentiel. Sans entraves ni préjugés. Visualisons un futur où la seule boussole de la recherche est la guérison, et non la rentabilité. C’est un futur que nous devons construire ensemble.
Retenez ceci:
- L’ivermectine et le fenbendazole: des molécules anciennes aux promesses anticancéreuses prometteuses in vitro et précliniques.
- Le financement de la recherche est le principal obstacle: les molécules génériques et non brevetables sont délaissées.
- L’absence d’essais cliniques majeurs chez l’humain n’est pas une preuve d’inefficacité. C’est le symptôme d’un système.
- Une recherche indépendante, transparente et affranchie des conflits d’intérêts est cruciale.
- Les patients méritent que toutes les pistes thérapeutiques soient explorées, au-delà de la rentabilité.

Perspectives et appel à l’action
L’histoire de l’ivermectine et du fenbendazole face au cancer est plus qu’une anecdote. C’est un miroir tendu à notre système de santé. Il questionne les priorités de la recherche médicale.
Le potentiel de ces molécules est là, inscrit dans des milliers de pages de publications scientifiques. Il demande juste à être pleinement exploré. Sans pression. Sans préjugés. Pour le bénéfice de tous.
Engageons-nous collectivement à soutenir une science véritablement indépendante. Une science qui ose regarder au-delà des profits. Une science qui ose chercher la vérité.
Qu’en pensez-vous?
Avez-vous déjà entendu parler de ces pistes de recherche?
Partagez vos réflexions, vos expériences ou vos questions dans les commentaires ci-dessous.
Votre voix est essentielle pour briser le silence et alimenter un débat public nécessaire et constructif.






















